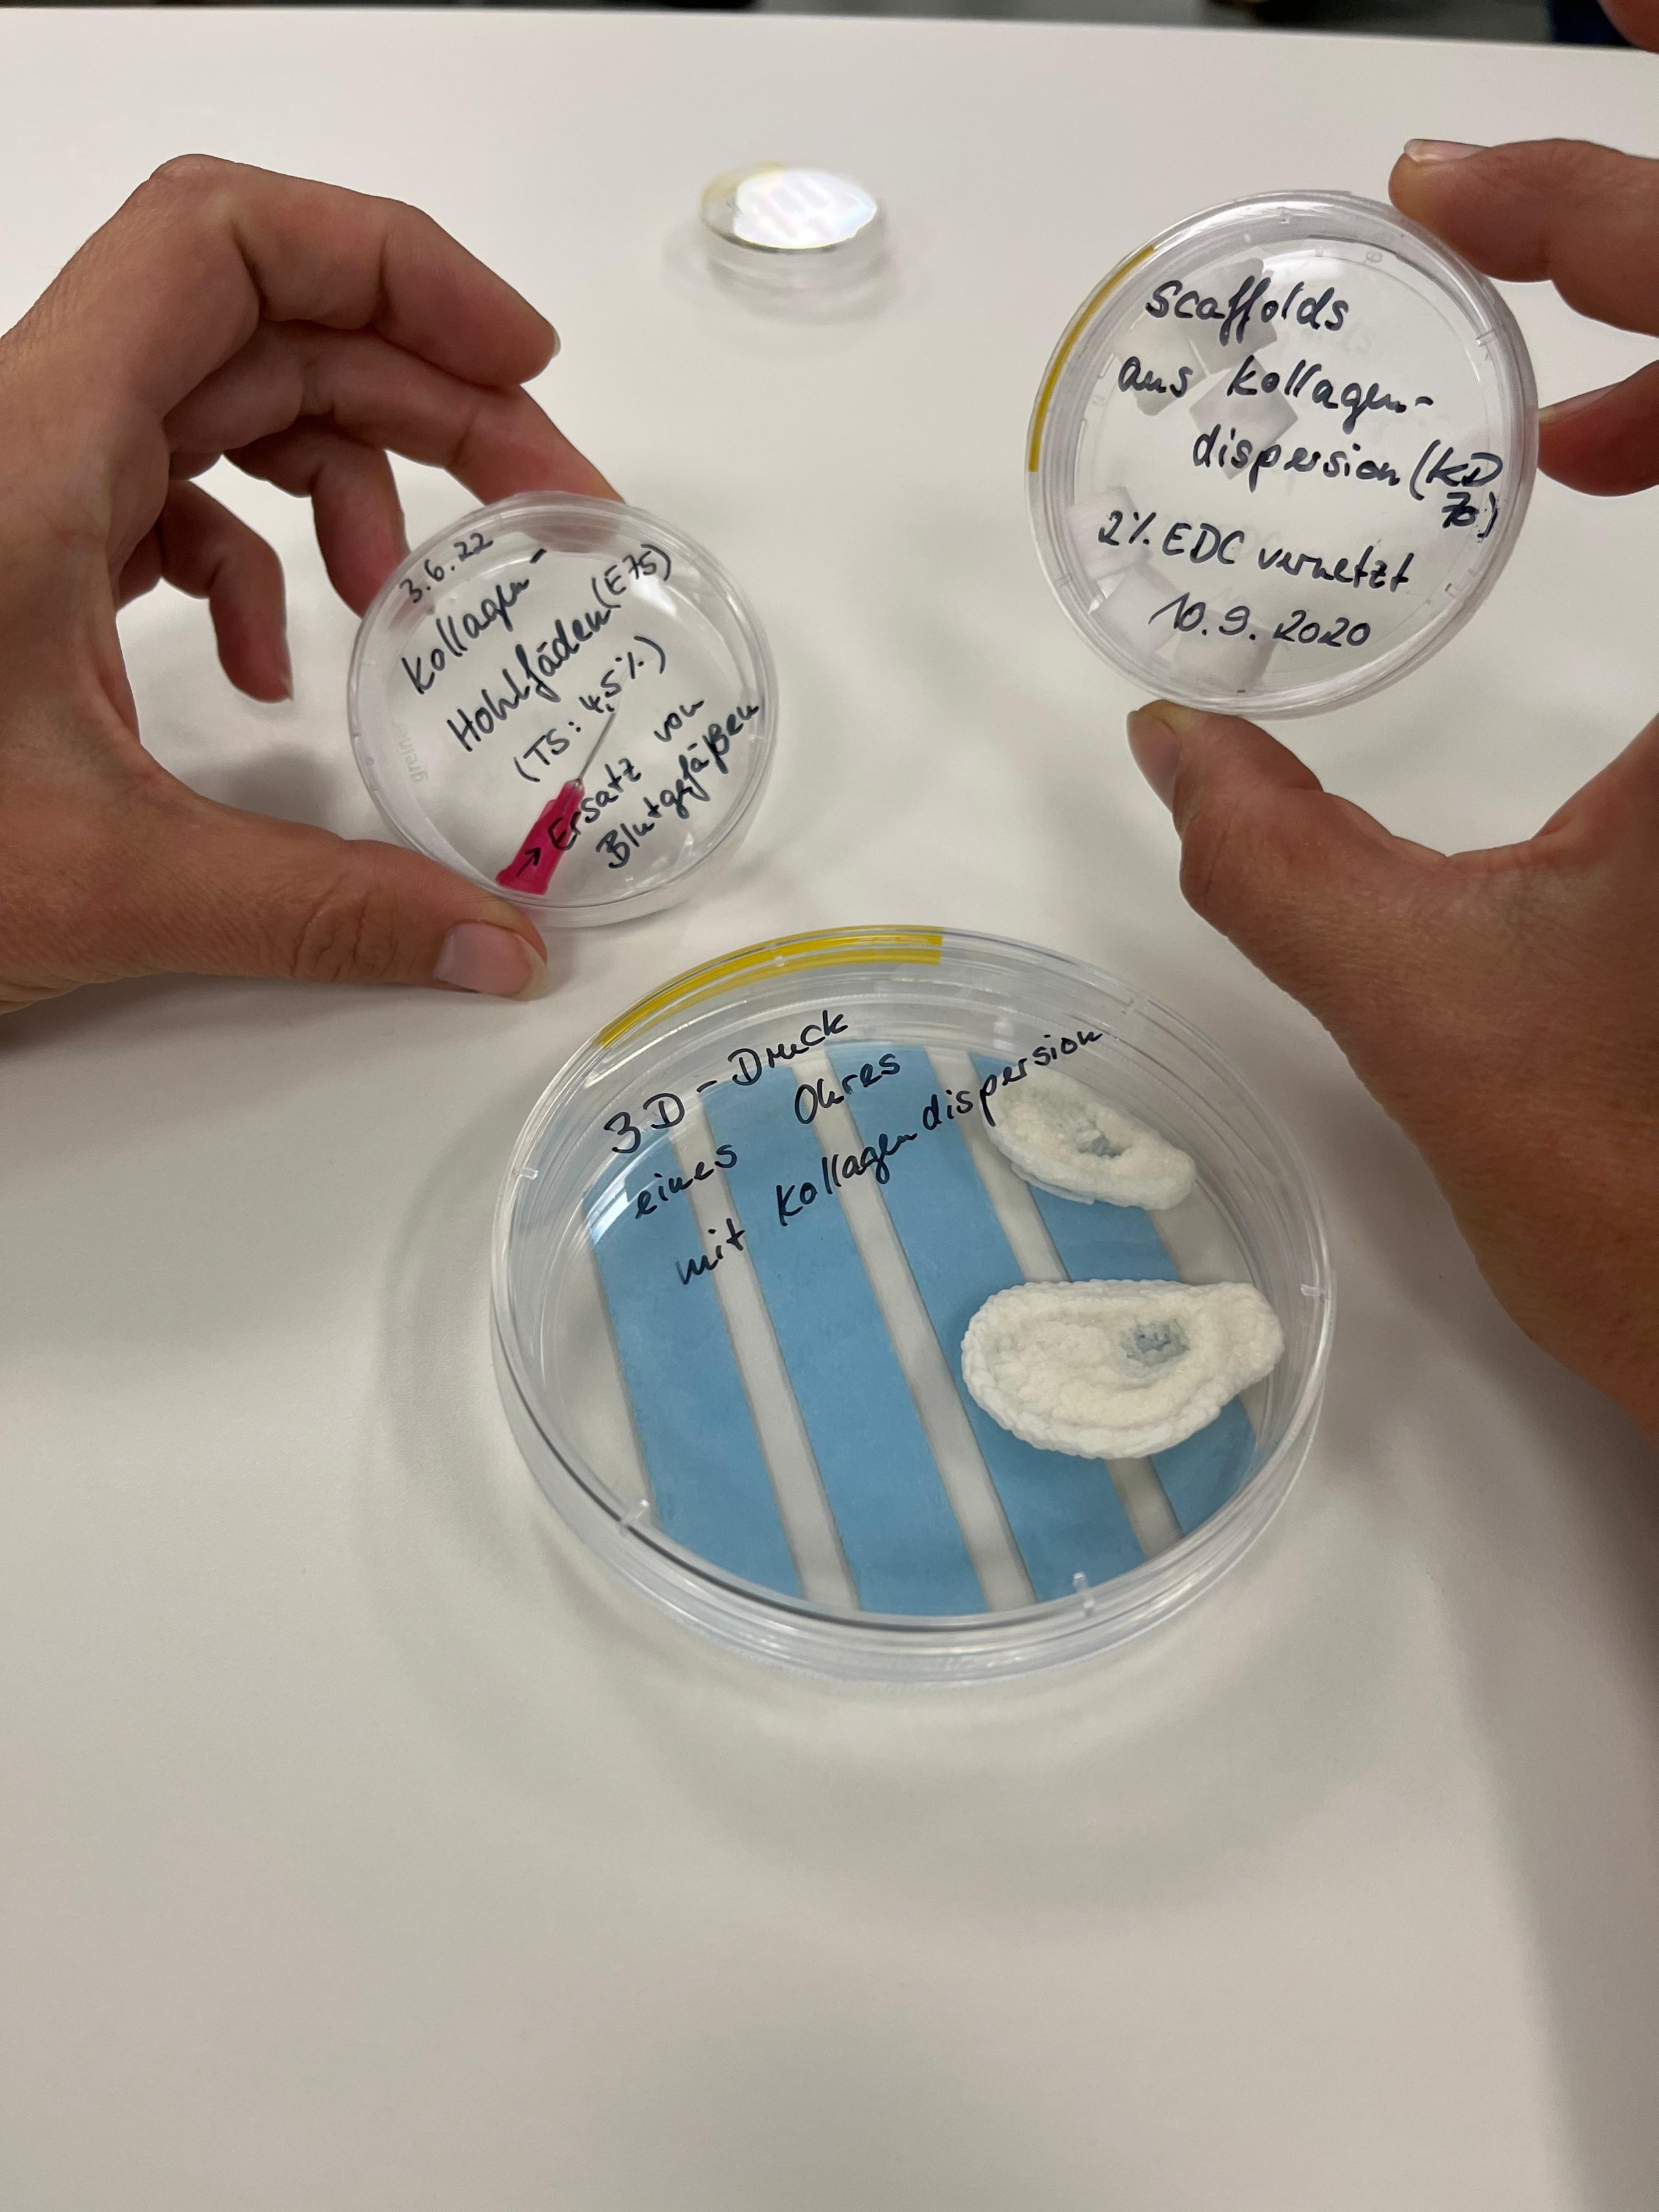

#block1764
Sterile technology network
This group meets 1-2 times a year, hosted in turn by different members. Its goal is to foster open discussions on technically relevant topics in the field of sterilization and related issues such as e-beam, medical device sterilization, logistics or the sterilization of polymers.
Meeting hosted by STERIS Company | Synergy Health Radeberg GmbH (Radeberg)
TOPIC: "Entwicklung von Medizinprodukten - Ist Sterilisation ein MUSS?"
Meeting hosted by the Leibniz Institute of Polymer Research Dresden IPF (Dresden)
TOPIC: "Polymere in der Medizintechnik - sterilisiere ich noch oder vernetze ich schon?"
Meeting hosted by cencora World Courier (Leipzig)
TOPIC: "Sensible medizinische Produkte - die Faszination der Sterilisation und Logistik"
Meeting hosted by FILK Freiberg Institute gGmbH (Freiberg)
TOPIC: "Biomaterialien & Sterilisation: Standards, Strategien, Lösungen"